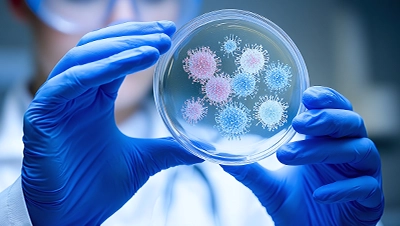
微生物検査

-
SOLTIMO

あなたの代わりに微生物の成長を観察し続けます

微生物の成長を素早く、正確に捉えます
直径90mmのシャーレ全体をカバーする大型光センサーが常に微生物の成長を観察し続けることで、些細な変化も逃さずキャッチします
解析結果を自動的にお知らせします
微生物の成長を連続的にモニタリングし、画像解析により微細な変化を見落とすことなくお知らせします

重ねて使えるコンパクトなサイズ
測定ユニットは小型、薄型ですので、現在お使いの微生物培養装置(インキュベーター)の中に重ねて設置することができ、複数のシャーレを同時に観察できます
製品紹介
医療機器はこちら
ご使用例

創薬
微生物検査

食の安全

ペットの健康

健康管理

環境モニタリング
SOLTIMOに関するお問い合わせは
こちらより承ります。

